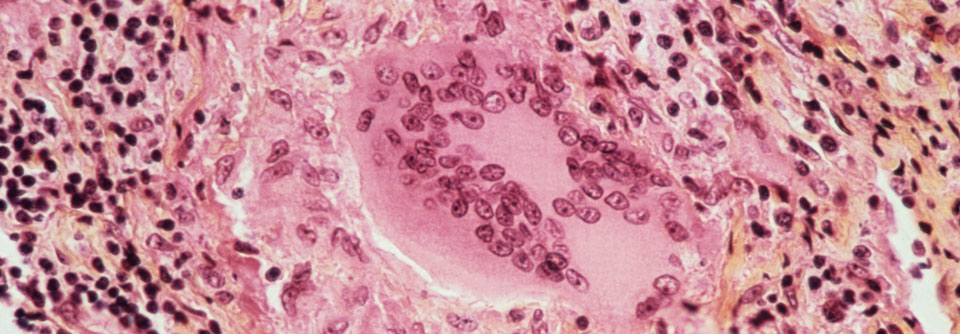

Kardiale Sarkoidose „Das Wichtigste ist, daran zu denken“
 Die Herz-MRT ist ein wichtiger Baustein bei der Diagnose der kardialen Sarkoidose.
© Science Photo Library/Cavallini, James
Die Herz-MRT ist ein wichtiger Baustein bei der Diagnose der kardialen Sarkoidose.
© Science Photo Library/Cavallini, James
Die wachsende Rolle der kardialen MRT, aber auch eine höhere Aufmerksamkeit haben die Inzidenz der kardialen Sarkoidose in den letzten Jahren ansteigen lassen. Beschrieben ist eine klinisch manifeste Herzbeteiligung bei ca. 5 % aller Sarkoidosepatienten. Zudem liegt „gar nicht so selten“ ein isolierter Herzbefall vor, wie Prof. Dr. Lars Eckardt vom Universitätsklinikum Münster ausführte.
Häufigstes Erstsymptom war höhergradiger AV-Block
Vier von fünf Betroffenen sterben am plötzlichen Herztod (SCD). Das ergab eine Fallserie aus Finnland mit 351 Patienten. Häufigstes Erstsymptom war allerdings ein höhergradiger AV-Block (42 % der Fälle). Der fatale oder überlebte SCD sowie eine ventrikuläre Tachykardie (VT) als primäre Manifestation betrafen je 14 %. Als Zwischenfazit hielt Prof. Eckardt fest, bei jungen Leuten mit höhergradigem AV-Block nicht direkt einen Schrittmacher zu implantieren. „Es könnte immer eine kardiale Sarkoidose dahinterstecken.“
Zu den weiteren rhythmologischen Auffälligkeiten zählen dem Referenten zufolge ein atypischer Rechtsschenkelblock und vermehrte ventrikuläre Extrasystolen. Vor allem in Kombination mit Kammertachykardien und Herzinsuffizienz in der Anamnese deuten Erregungsleitungsstörungen auf eine Sarkoidose im Herzen hin. „Das Wichtigste ist wie so oft, überhaupt daran zu denken“, so Prof. Eckardt.
Da sich die Erkrankung auch vorwiegend rechtsventrikulär abspielen kann, bereitet die Abgrenzung zur arrhythmogenen rechtsventrikulären Kardiomyopathie (ARVC) mitunter Probleme. Die Sarkoidose wird dann oft fehlgedeutet. Prof. Eckardt plädierte für eine MR-Bildgebung, die häufig schon sehr charakteristische Muster aufdeckt. Diagnostisch helfen zudem Herzmuskelbiopsie und Positronen-Emissions-Tomografie weiter. Die Echokardiografie sei meist nicht wegweisend, betonte der Kollege. Im ungünstigsten Fall sehe man sogar einen normalen linken Ventrikel und könne den rechten nicht wirklich beurteilen.
Schwierig wird es bei der Frage, welcher Patient einen implantierbaren Kardioverter-Defibrillator (ICD) braucht. In den europäischen Leitlinien zum plötzlichen Herztod besteht nach überlebtem SCD, bei anhaltender VT oder einer linksventrikulären Ejektionsfraktion ≤ 35 % eine Klasse-I-Empfehlung zur Implantation. Abseits davon hat die Risikostratifizierung in den Leitlinien Schwächen, besonders wenn es um die Identifikation eines prognostisch eher gutartigen Herzbefalls geht. Das unterstreicht eine weitere Studie aus Finnland mit 398 Patienten mit kardialer Sarkoidose. Etwa jeder Zweite hatte eine histologisch gesicherte Diagnose, bei den übrigen war sie aufgrund der Klinik warscheinlich. Im medianen Follow-up von 4,8 Jahren erlitten 10 % einen fatalen oder nicht-tödlichen SCD.
Erfüllten die Teilnehmer die Kriterien für eine Klasse-I/IIa-Empfehlung* zur ICD-Implantation, betrug die 5-Jahres-Inzidenz für den SCD 11 %. Beschränkt auf die histologisch gesicherten Fälle lag die Rate bei 14 %. „Da würden Sie sagen: Diese Patienten profitieren vom Defi“, kommentierte Prof. Eckardt. Teilnehmer ohne Klasse-I/IIa-Indikation hatten immerhin noch eine SCD-Inzidenz von 5 % bzw. 6 %. Das wiederum sind Ereignisraten, „wo Sie bei vielen Erkrankungen ohne zu zögern einen Defi implantieren würden“, meinte der Kollege. Der Trend gehe vor allem in den USA hin zu einem großzügigen ICD-Einsatz. „Vielleicht ist es im Einzelfall eine Übertherapie. Aber an dieser Stelle lieber einmal übertherapiert, als einen jungen Patienten mit Sarkoidose zu verlieren.“
* gemäß der US-amerikanischen Leitlinie
Quelle: 19. DGK-Kardiologie-Update-Seminar